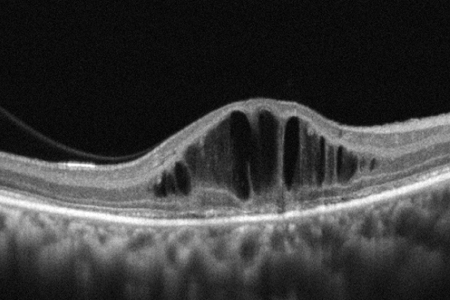
BB
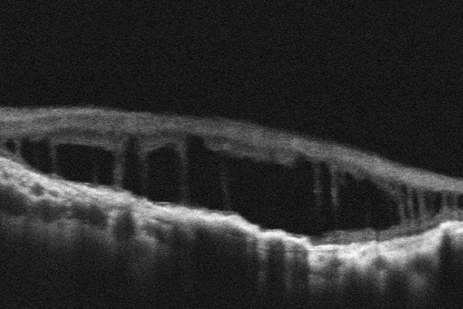
BB

BB BB
作者 汪正翔 Author Sean Wang
媒材 攝影 Medium Photography
年份 2022 Year 2022
尺寸 20 x 150 cm Size 20 x 150 cm
作品賞析 Artwork Appreciation
有一天我在公館搭捷運,通過捷運閘門的時候發出BB兩聲。忽然有一個服務人員把我攔下來,核對我愛心悠遊卡上面的照片與我本人的長相,可能因為我看起來不像是視障。查完之後,她問我要不要刷一下卡,這樣以後就不會響兩聲。我一時之間沒有意會過來,我的卡片就已經被處理好了。從那時開始,當我通過捷運的時候,我永遠都跟正常人一樣,只發出Bㄧ聲。為了找回屬於我的第二聲B,我打造了一個閘門,這個閘門將根據人的生理特徵,發出BB的聲音。同時為了證明我是一個視障,我將在展覽當中提出我是視障的證據。
One day, I took the MRT at Gongguang. When I swiped the card at the gate sensor, it beeped twice. Suddenly a staff member stopped me and compared the photo on my disability card with my appearance. Maybe it was because I didn’t look like a visually-impaired person. After checking, she asked me to swipe the card again and said it wouldn’t beep twice in the future. I didn’t realize that my card had been adjusted. Afterwards, when I would pass the faregates, my card would only beep once like a normal card. In order to retrieve my second beep, I’ve built a gate that will beep based on people’s physical traits. To prove that I am visually-impaired, I will present the proof at the exhibition.